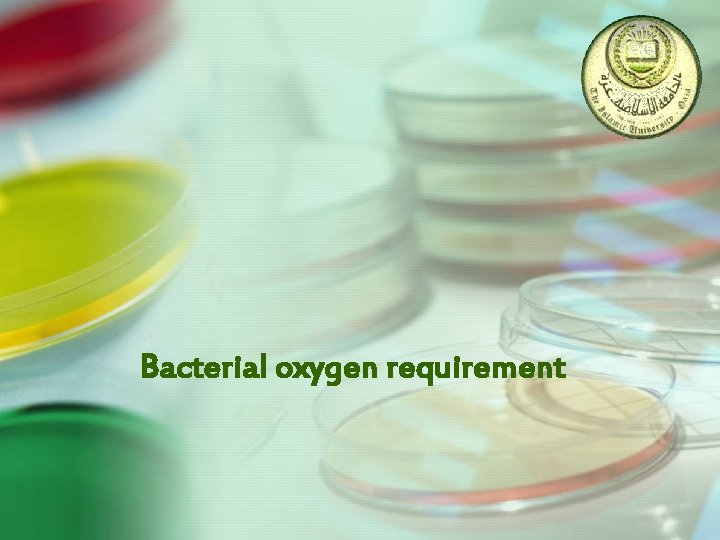
Bacterial oxygen requirement
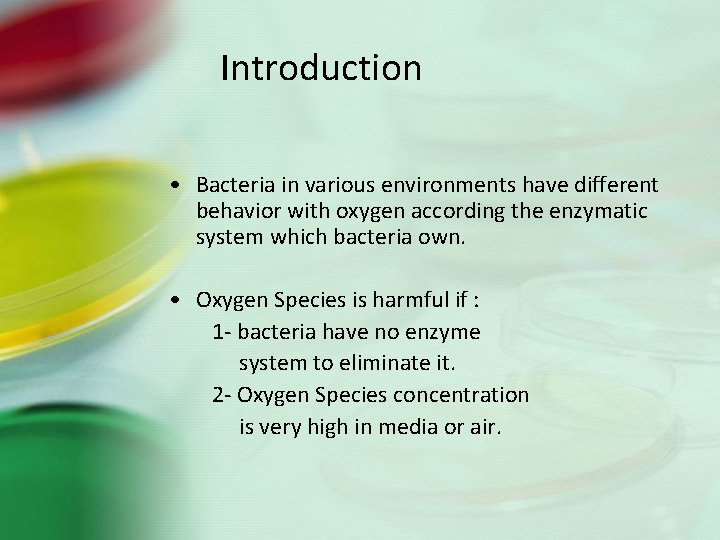
Introduction • Bacteria in various environments have different behavior with oxygen according the enzymatic
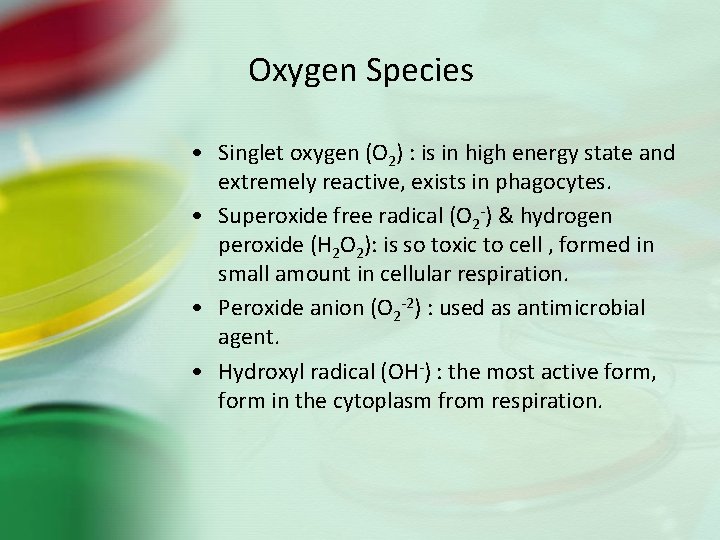
Oxygen Species • Singlet oxygen (O 2) : is in high energy state and
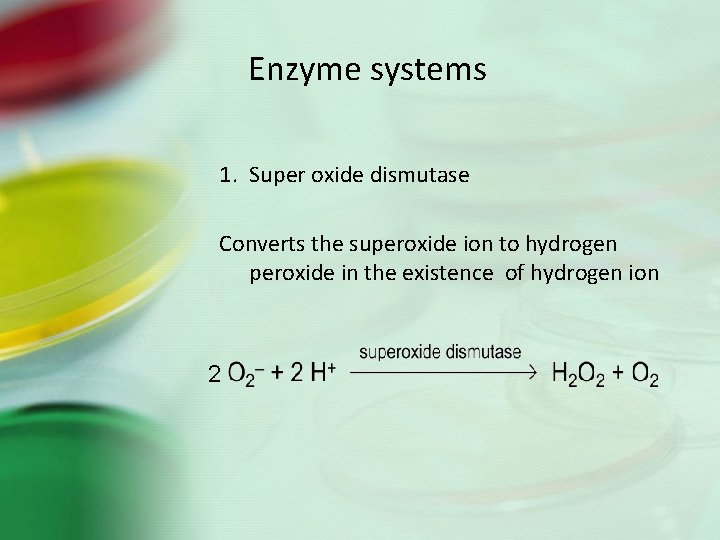
Enzyme systems 1. Super oxide dismutase Converts the superoxide ion to hydrogen peroxide in
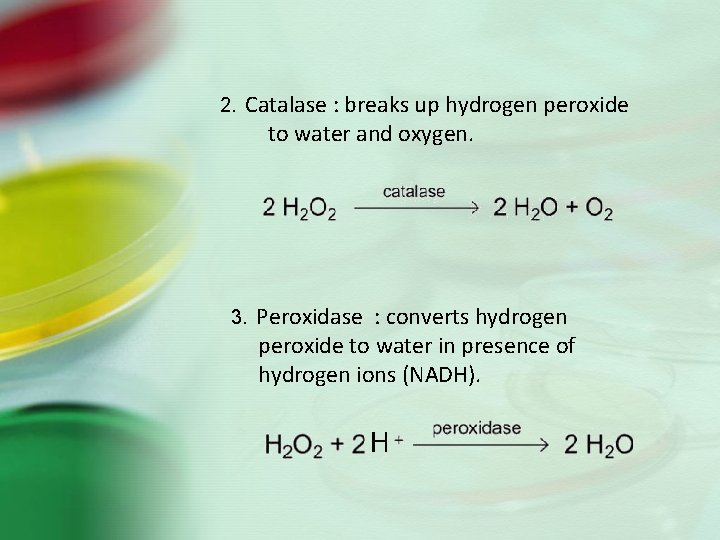
2. Catalase : breaks up hydrogen peroxide to water and oxygen. 3. Peroxidase :
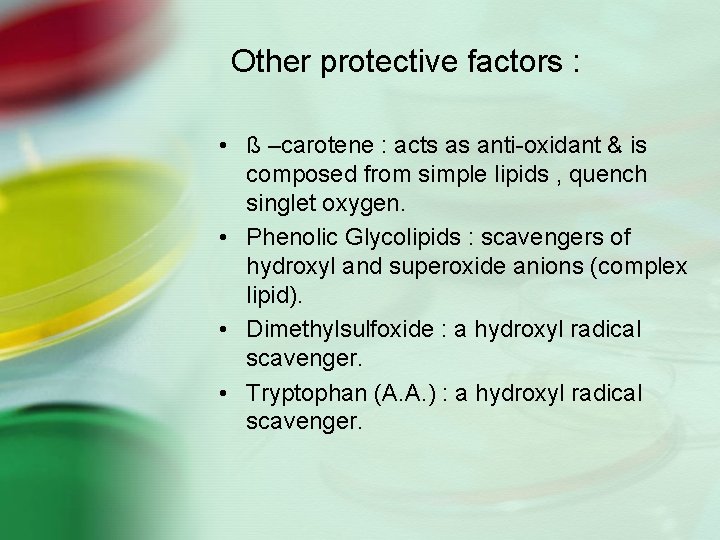
Other protective factors : • ß –carotene : acts as anti-oxidant & is composed
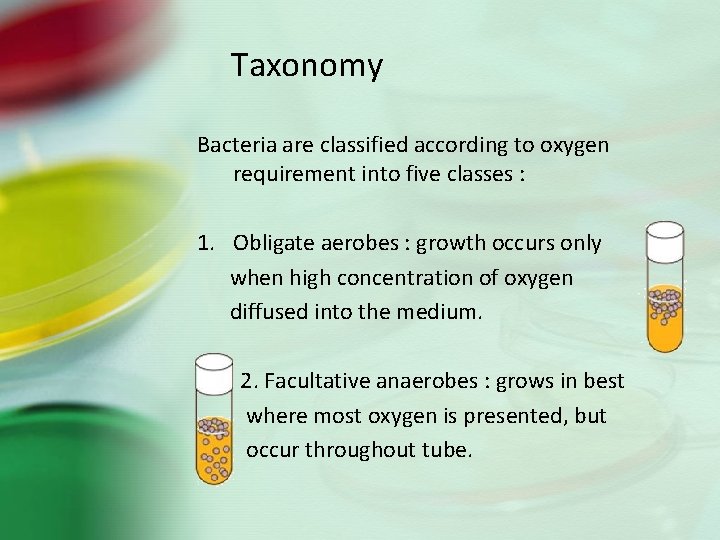
Taxonomy Bacteria are classified according to oxygen requirement into five classes : 1. Obligate
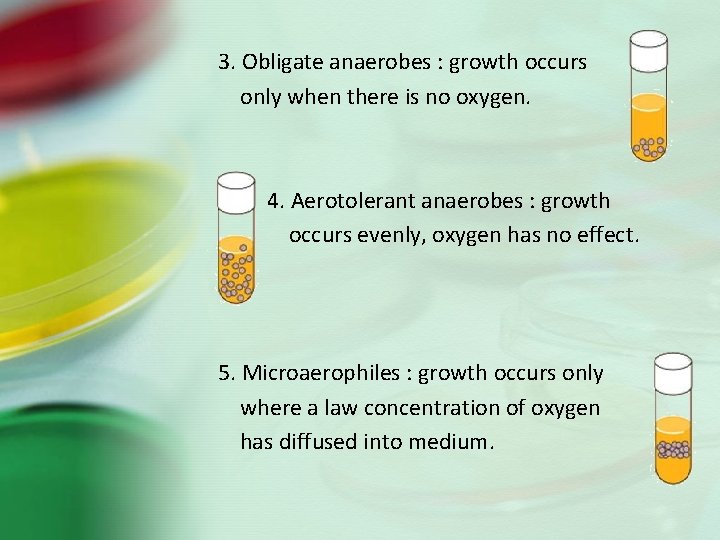
3. Obligate anaerobes : growth occurs only when there is no oxygen. 4. Aerotolerant
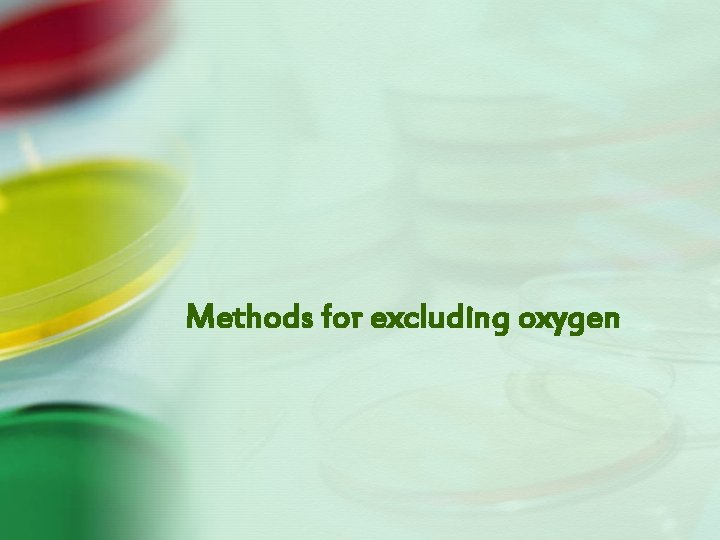
Methods for excluding oxygen

Bacterial oxygen requirement Introduction Bacteria in various environments
Bacterial oxygen requirement
Introduction • Bacteria in various environments have different behavior with oxygen according the enzymatic system which bacteria own. • Oxygen Species is harmful if : 1 - bacteria have no enzyme system to eliminate it. 2 - Oxygen Species concentration is very high in media or air.
Oxygen Species • Singlet oxygen (O 2) : is in high energy state and extremely reactive, exists in phagocytes. • Superoxide free radical (O 2 -) & hydrogen peroxide (H 2 O 2): is so toxic to cell , formed in small amount in cellular respiration. • Peroxide anion (O 2 -2) : used as antimicrobial agent. • Hydroxyl radical (OH-) : the most active form, form in the cytoplasm from respiration.
Enzyme systems 1. Super oxide dismutase Converts the superoxide ion to hydrogen peroxide in the existence of hydrogen ion 2
2. Catalase : breaks up hydrogen peroxide to water and oxygen. 3. Peroxidase : converts hydrogen peroxide to water in presence of hydrogen ions (NADH).
Other protective factors : • ß –carotene : acts as anti-oxidant & is composed from simple lipids , quench singlet oxygen. • Phenolic Glycolipids : scavengers of hydroxyl and superoxide anions (complex lipid). • Dimethylsulfoxide : a hydroxyl radical scavenger. • Tryptophan (A. A. ) : a hydroxyl radical scavenger.
Taxonomy Bacteria are classified according to oxygen requirement into five classes : 1. Obligate aerobes : growth occurs only when high concentration of oxygen diffused into the medium. 2. Facultative anaerobes : grows in best where most oxygen is presented, but occur throughout tube.
3. Obligate anaerobes : growth occurs only when there is no oxygen. 4. Aerotolerant anaerobes : growth occurs evenly, oxygen has no effect. 5. Microaerophiles : growth occurs only where a law concentration of oxygen has diffused into medium.

class Aspects Energy source Obligate aerobes Facultative anaerobes Obligate anaerobes Aerotolera - Microaeropnt hiles anaerobes cellular respiration, fermentation, fermentation autotrophy Bacillus, Pseudomonas E. coli, Staphylococcus Clostridium tetani, Bacteroides cellular respiration aerobic anaerobic SOD enzyme Peroxidase catalase example Lactobacillus Campylobacter & Heliobacter pylori
Methods for excluding oxygen

Fluid Thioglycollate Media (FTM) supports aerobic & anaerobic bacteria • – Sodium thioglycollate and cyctine removes O 2 from the medium • – Resazurin as an oxidation reduction indicator turns pink in presence of O 2 • Small amount of agar presented to retard gases

Gas Pack System : Anaerobic Jar


Gas Pak Pouch • Procedure for Gas. Pak Pouch. (a) Dispense Gas. Pak liquid activating reagent into channel of pouch. (b) Place plates inside the pouch. (c) Lock in anaerobic environment with sealing bar and incubate.

Candle jars • The candle flame will consume most of the oxygen in the jar. • Produce an elevated level of carbon dioxide. • These conditions are ideal for the growth of campilophilic and microaerophilic organisms.

CO 2 Generating Packet

Anaerobic Chambers • The Vinyl Anaerobic Chambers provide a strict anaerobic atmosphere using a palladium catalyst and hydrogen gas mix of 5%.
- Slides: 17